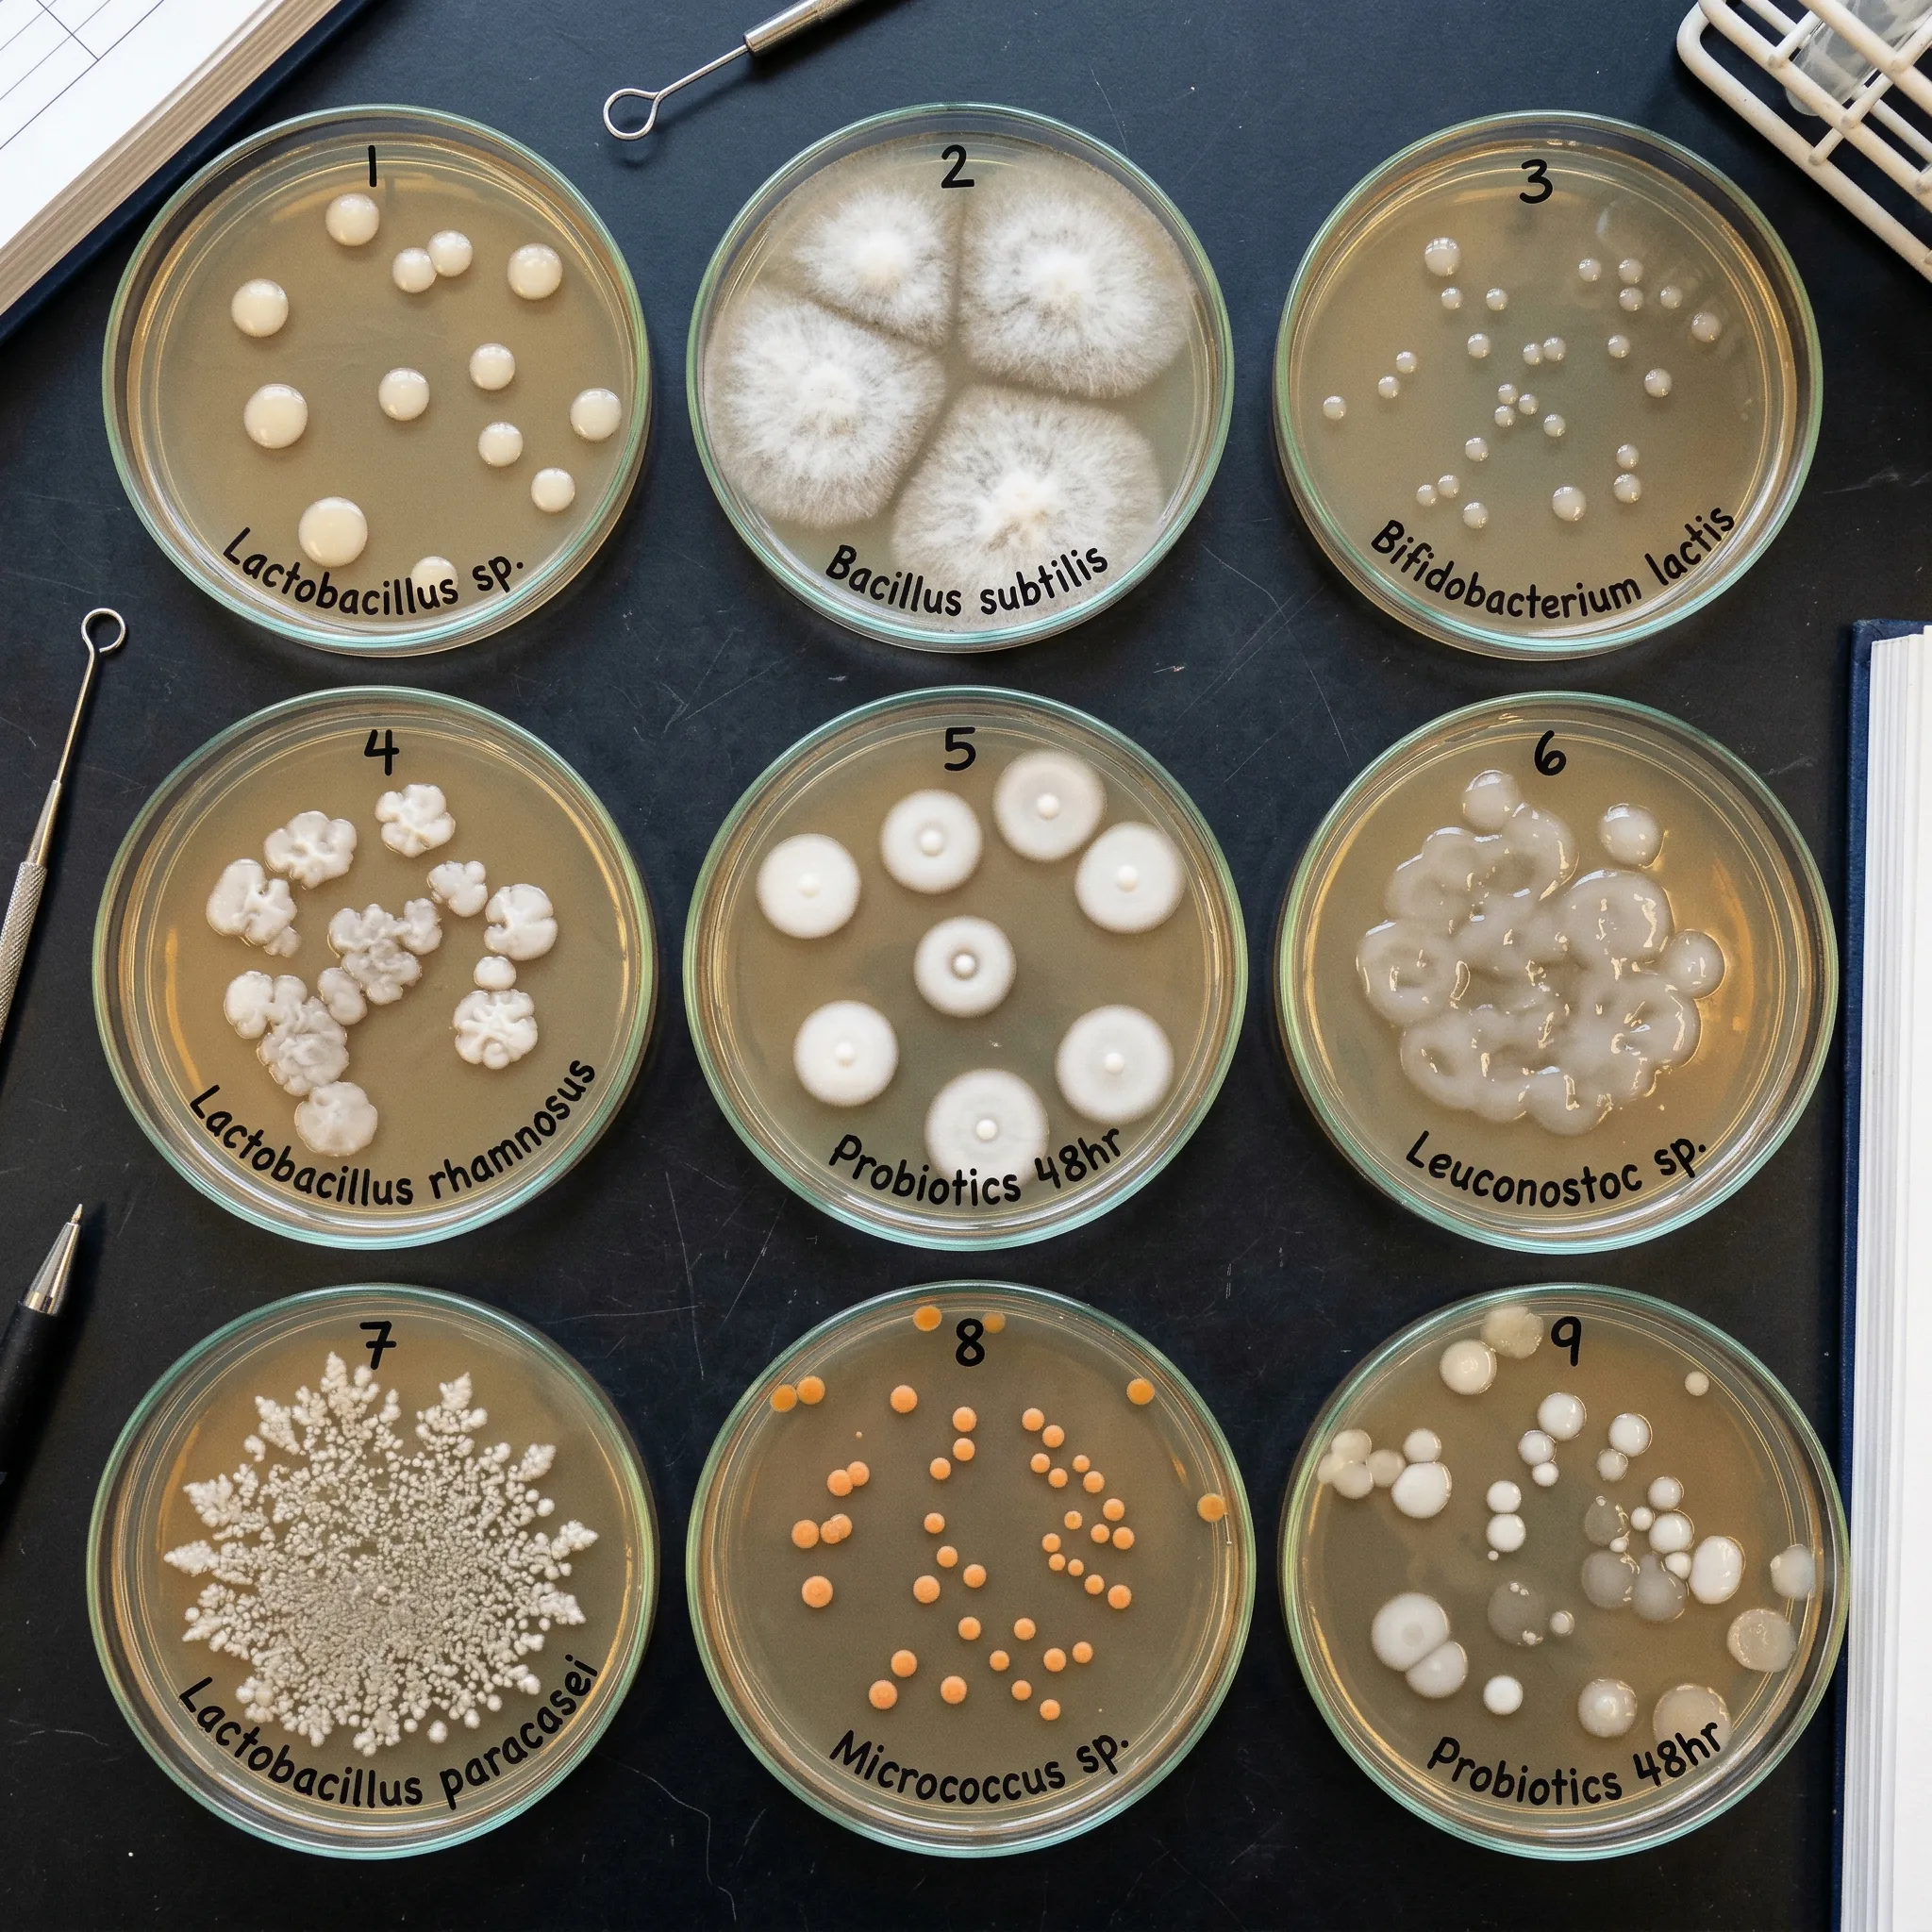
Close-up of different probiotic bacterial colonies growing on agar plates with distinct morphologies and colors

A pill full of bacteria that changes how you feel?
In 2013, psychiatrist Ted Dinan and neuroscientist John Cryan at University College Cork coined a word that sounded like science fiction: psychobiotics. They defined them as live organisms that, when ingested in adequate amounts, produce a health benefit in patients suffering from psychiatric illness. The term has since broadened. A 2025 narrative review in Experimental Physiology now includes microbe-derived metabolites and dead bacterial preparations that interact with the microbiota-gut-brain axis.
The idea is simple but hard to accept at first: swallowing specific bacterial strains could influence your mood, stress response, and cognitive function. Not by magic, but through measurable biological pathways that researchers have spent the last decade mapping.
This is a different conversation from the general gut-brain axis discussion. Rather than asking "does the gut affect the brain?" (it does), we're asking something more specific: which exact strains, at what doses, produce what measurable changes in anxiety, depression, or cognitive performance?
The honest answer sits between the hype and the dismissal. Some strains have real human data behind them. Others have been tested and failed. And most have never been tested for brain effects at all.
Four routes from your intestines to your neurons
To make sense of strain-specific research, it helps to understand how bacteria in your lower intestine could possibly influence tissue inside your skull. Four documented communication routes exist, and most psychobiotics use more than one.

The vagus nerve highway. The vagus nerve runs from your brainstem to your gut, carrying signals in both directions. In the study that launched this entire field, Bravo et al. at University College Cork fed mice Lactobacillus rhamnosus JB-1 and observed altered GABA receptor expression across multiple brain regions (Proceedings of the National Academy of Sciences, 2011). GABA is the brain's primary calming neurotransmitter. The mice showed reduced anxiety- and depression-like behaviors and lower stress hormone levels. When the researchers severed the vagus nerve, every single effect disappeared. The bacteria needed the vagus nerve to reach the brain.
Immune system signaling. Gut bacteria influence the production of pro-inflammatory and anti-inflammatory cytokines. Chronic low-grade inflammation is linked to depression, and certain probiotic strains appear to shift the balance. A 2023 meta-analysis of randomized controlled trials found that probiotic supplementation significantly reduced C-reactive protein levels (a marker of systemic inflammation) in depressed patients with comorbid conditions, with a standardized mean difference of -0.47.
The stress hormone axis. Your hypothalamic-pituitary-adrenal (HPA) axis controls cortisol release. Multiple psychobiotic strains have been shown to dampen exaggerated cortisol responses. When healthy volunteers took Bifidobacterium longum 1714 for four weeks, their cortisol output during a social stress test dropped significantly compared to placebo (Allen et al., Translational Psychiatry, 2016).
Metabolite production. Gut bacteria produce neurotransmitter precursors and short-chain fatty acids. Some strains produce GABA directly; others generate butyrate, which strengthens the intestinal barrier and reduces the "leaky gut" that can drive neuroinflammation. The same meta-analysis found probiotics significantly increased brain-derived neurotrophic factor (BDNF) levels (SMD = 0.37, p = 0.02), a protein essential for neuron growth and synaptic plasticity.
The strains with actual human evidence
Most probiotic supplements contain strains chosen for shelf stability or digestive benefits, not for brain effects. Psychobiotic research focuses on a handful of strains tested in controlled human trials. Two bacteria from the same species can have completely different effects, which makes the strain designation the single most important detail on any psychobiotic label.
| Strain | Key human finding | Study type | Duration |
|---|---|---|---|
| Bifidobacterium longum 1714 | Reduced cortisol output, daily stress, improved visuospatial memory | Controlled clinical trial, N=22 | 4 weeks |
| L. helveticus R0052 + B. longum R0175 | Reduced anxiety, psychological distress, urinary cortisol | RCT, N=55 | 30 days |
| Lactiplantibacillus plantarum PS128 | Improved stress, anxiety, depression, sleep quality, reduced cortisol | Open-label, N=36 | 8 weeks |
| Lacticaseibacillus rhamnosus HN001 | 39% moved from not-happy to happy vs 29% placebo | RCT, N=120 | 28 days |
| L. rhamnosus JB-1 | No effect on mood, anxiety, stress, or cognition in healthy men | RCT crossover, N=29 | 8 weeks |
Bifidobacterium longum 1714. This is arguably the best-studied single psychobiotic strain. Allen and colleagues at University College Cork ran a within-subjects trial where 22 healthy volunteers completed stress tests and cognitive assessments at baseline, after placebo, and after taking the strain. Cortisol output during a social stress test dropped. Daily reported stress decreased. Visuospatial memory improved slightly. A follow-up randomized, double-blind, placebo-controlled trial with 40 volunteers (Wang et al., Neurogastroenterology & Motility, 2019) confirmed the strain modulated resting brain activity, increasing theta and alpha band power in the frontal and cingulate cortex, regions involved in emotional regulation and cognitive control. Participants taking the probiotic reported enhanced vitality and reduced mental fatigue.
L. helveticus R0052 + B. longum R0175. This combination was tested in one of the earliest human psychobiotic trials. Messaoudi and colleagues (British Journal of Nutrition, 2011) gave the pair to healthy volunteers for 30 days. Global psychological distress scores dropped significantly (p < 0.05 on the Hopkins Symptom Checklist), including somatization, depression, and anger-hostility subscales. Urinary free cortisol also decreased. A 2023 RCT with 135 healthy adults confirmed this combination's effects, but with a catch: the benefits only reached significance in participants who already maintained healthy lifestyle behaviors. People with poor diets and sedentary habits didn't respond.
L. plantarum PS128. Developed by Taiwanese researchers, this strain was tested in high-stress IT specialists (Wu et al., Frontiers in Nutrition, 2021). After eight weeks of supplementation at 20 billion CFU daily, participants showed significant improvements in perceived stress, job stress, anxiety, depression, and sleep quality. Salivary cortisol levels dropped. This was an open-label study (no placebo group), which limits its conclusions, but the cortisol measurements add objective data to the self-report findings.
L. rhamnosus HN001. A 2024 double-blind RCT with 120 adults experiencing mild to high stress found that 39% of HN001 recipients moved from "not happy" to "happy" on the Oxford Happiness Questionnaire after 28 days, compared to 29% in the placebo group. The overall between-group differences didn't reach statistical significance in the primary analysis, but a post-hoc analysis found significant interaction effects for both happiness (p = 0.014) and perceived stress (p = 0.043) scores over time.
23 RCTs later: what Canada's psychiatric guidelines conclude
In 2025, the Canadian Network for Mood and Anxiety Treatments (CANMAT) convened a task force specifically to evaluate probiotics for major depressive disorder. They reviewed 23 randomized controlled trials and eight meta-analyses (Canadian Journal of Psychiatry, 2025). Their conclusion was measured: probiotics have demonstrated "modest improvements in depressive symptoms, particularly when used in an adjunctive manner," but recent high-quality trials yielded mixed results.
The CANMAT task force recommended probiotics as third-line adjunctive treatment for major depressive disorder, meaning they should be considered only after first- and second-line treatments have been tried. There is currently insufficient evidence for prebiotics, synbiotics, or fecal microbiota transplantation.
Five years ago, most psychiatrists would have dismissed probiotics for depression outright. A major psychiatric guideline body now includes them, cautiously, as an option worth considering. That shift in tone is worth paying attention to.
The comprehensive review covering 2014-2023 reaches a similar conclusion: the majority of recent literature supports a beneficial role for probiotics in treating depression and anxiety, but with important gaps in understanding mechanisms, optimal dosing, timing, and which patient subgroups respond best.
| Outcome measured | Finding from meta-analyses | Confidence level |
|---|---|---|
| Depression symptoms (adjunctive) | Modest improvement vs placebo | Moderate (mixed results in recent trials) |
| BDNF levels | Significant increase (SMD 0.37) | Moderate |
| CRP (inflammation marker) | Significant decrease (SMD -0.47) | Moderate (only in patients with comorbidities) |
| Anxiety in youth | No significant effect (SMD -0.03) | Low (high heterogeneity, small samples) |
| Cortisol response to stress | Reduced in multiple strain-specific trials | Moderate |
A systematic review of psychobiotic interventions for anxiety in young people (10 RCTs, 617 total subjects) found a pooled effect size of essentially zero (SMD = -0.03). After removing high-bias studies, the effect nudged to -0.16 but still wasn't statistically significant. Age may matter: the gut-brain axis is still developing in adolescence, and the doses tested in adults may not apply.
The JB-1 problem: what works in mice might not work in you
The story of Lactobacillus rhamnosus JB-1 is a necessary reality check. The 2011 Bravo study in mice was extraordinary: clear GABA receptor changes, reduced anxiety behaviors, lower corticosterone, all abolished by vagotomy. It launched hundreds of citations and an entire research direction.
Then came the human trial. Kelly and colleagues (2017) ran an 8-week randomized, placebo-controlled crossover study with 29 healthy male volunteers. They measured mood, anxiety, stress, sleep quality, cognitive performance, EEG patterns, and inflammatory cytokines. The result: nothing. No effect on any measure. Not a trend, not a near-miss, just complete absence of the effects seen in mice.

| What mouse studies showed (JB-1) | What human studies showed (JB-1) |
|---|---|
| Altered GABA receptor expression in multiple brain regions | No significant EEG changes |
| Reduced anxiety-like behavior (elevated plus maze, forced swim) | No change in anxiety, mood, or stress measures |
| Lower stress-induced corticosterone | No change in cortisol response to social stress |
| Enhanced fear conditioning memory | No cognitive improvements |
| All effects vagus nerve-dependent | Not tested (but irrelevant given null results) |
Why the disconnect? Several factors likely contribute. The mouse strain used (BALB/c) is inherently anxious, so there was more room for improvement. The human participants were healthy, not clinically anxious or depressed. Dosing, gut transit, and colonization patterns differ between species. And the behavioral measures used in mice (time spent in open areas, swimming endurance) are crude proxies for human emotional states.
The lesson isn't that psychobiotics are fake. It's that strain selection matters, testing populations matter, and animal results need human validation before anyone should take them seriously. B. longum 1714, for instance, showed positive results in both mice and humans, suggesting its mechanisms translate better across species.
How to evaluate psychobiotic supplements (without getting scammed)
If you're considering psychobiotic supplementation based on this evidence, here's what the research suggests about practical use.
Look for specific strain designations. A label that says "Lactobacillus rhamnosus" without a strain code (like HN001, JB-1, or GG) tells you nothing about brain effects. The strain code is what links the product to specific clinical trials. Two strains of the same species can have opposite effects.
Check for CFU counts that match the research. Most positive psychobiotic trials used doses between 1 billion and 20 billion CFU daily. The B. longum 1714 studies used 1 x 10^9 CFU/day. PS128 was tested at 20 billion CFU/day. More is not necessarily better, but amounts below 1 billion CFU have little research support.
Duration matters. The 2025 review in Experimental Physiology notes that effects are typically observed over 4 to 12 weeks of consistent supplementation. Most positive trials saw initial changes around weeks 2-4. Expecting results in days is unrealistic.
Lifestyle behaviors amplify (or block) effects. The 2023 Morales-Torres RCT found that L. helveticus R0052 + B. longum R0175 only produced significant anxiety reduction in participants who already had healthy lifestyle behaviors, including a Mediterranean-style diet and regular physical activity. Psychobiotics work within a broader ecosystem. Taking them while eating processed food and sitting all day may produce nothing measurable.
The National Center for Complementary and Integrative Health notes that probiotics have a generally good safety profile in healthy people, with mild digestive symptoms being the most common side effect. However, they recommend caution for immunocompromised individuals and advise discussing any new supplement with your healthcare provider.
Current evidence positions psychobiotics as potential complements to, not replacements for, standard mental health care. The CANMAT task force places them as third-line adjunctive, meaning you'd use them alongside conventional treatments, not instead of them. If you're dealing with clinical depression or anxiety, a probiotic supplement is not a substitute for professional treatment.
The next phase of psychobiotic research will likely move toward precision: matching specific strains to individual gut profiles using metabolomics. Researchers are already running trials that screen participants' microbiome composition before randomization, hoping to identify who will respond. The connection between gut barrier integrity and systemic health gives psychobiotics a plausible biological foundation. But until those precision tools arrive, the practical takeaway is narrower: a few well-studied strains, at specific doses, for 4-12 weeks, as a complement to other treatment. That's where the evidence currently lands.
Frequently Asked Questions
Can psychobiotics replace antidepressants?
No. The CANMAT 2025 task force specifically positioned probiotics as third-line adjunctive treatments for major depressive disorder, meaning they should supplement existing treatment, not replace it. The effects observed in clinical trials are modest and inconsistent across studies. Anyone on antidepressant medication should consult their prescriber before making any changes.
How long do psychobiotics take to work?
Most clinical trials showing positive results used supplementation periods of 4 to 12 weeks. The L. rhamnosus HN001 study saw measurable changes by day 14, while B. longum 1714 showed effects after 4 weeks. Individual responses vary based on existing gut microbiome composition, diet, and lifestyle factors.
Are all probiotic strains psychobiotics?
No. The term psychobiotic applies only to strains with demonstrated effects on brain function or mental health outcomes. Most commercial probiotics contain strains selected for digestive health or shelf stability, not for neurological effects. Strain designation matters enormously: L. rhamnosus JB-1 failed in human mood studies, while L. rhamnosus HN001 showed positive results.
Are psychobiotics safe?
For healthy adults, the safety profile of studied psychobiotic strains is good. Side effects in clinical trials were minimal, typically limited to mild digestive discomfort. The National Center for Complementary and Integrative Health notes that probiotics may pose risks for severely immunocompromised individuals, people with critical illness, or those who have recently had surgery. Discuss supplementation with a healthcare provider if you have underlying health conditions.
Do psychobiotics work for children and teenagers?
Evidence is limited. A 2021 systematic review and meta-analysis of 10 RCTs in young people aged 10-24 found no significant effect of psychobiotic interventions on anxiety (pooled SMD of -0.03). The adolescent gut-brain axis is still developing, and doses and strains effective in adults may not apply to younger populations. More targeted research is needed.
Related Articles
- Gut-Brain Axis: How Your Microbiome Affects Mood and Cognition - The broader connection between gut health and mental function that psychobiotics aim to leverage.
- Health Benefits of Probiotics: An Evidence-Based Ultimate Guide - General probiotic benefits beyond mental health effects.
- Postbiotics vs. Probiotics vs. Prebiotics: The Complete Guide - Understanding the differences between these gut health interventions.
- Butyrate: The Gut Metabolite That Heals Your Colon and Protects Your Brain - One of the key metabolites produced by beneficial gut bacteria.
- Leaky Gut Syndrome: Symptoms, Causes, and Evidence-Based Healing - The gut barrier dysfunction that psychobiotics may help address.
Medical Disclaimer
This article is for informational and educational purposes only and is not medical advice, diagnosis, or treatment. Always consult a licensed physician or qualified healthcare professional regarding any medical concerns. Never ignore professional medical advice or delay seeking care because of something you read on this site. If you think you have a medical emergency, call 911 immediately.











